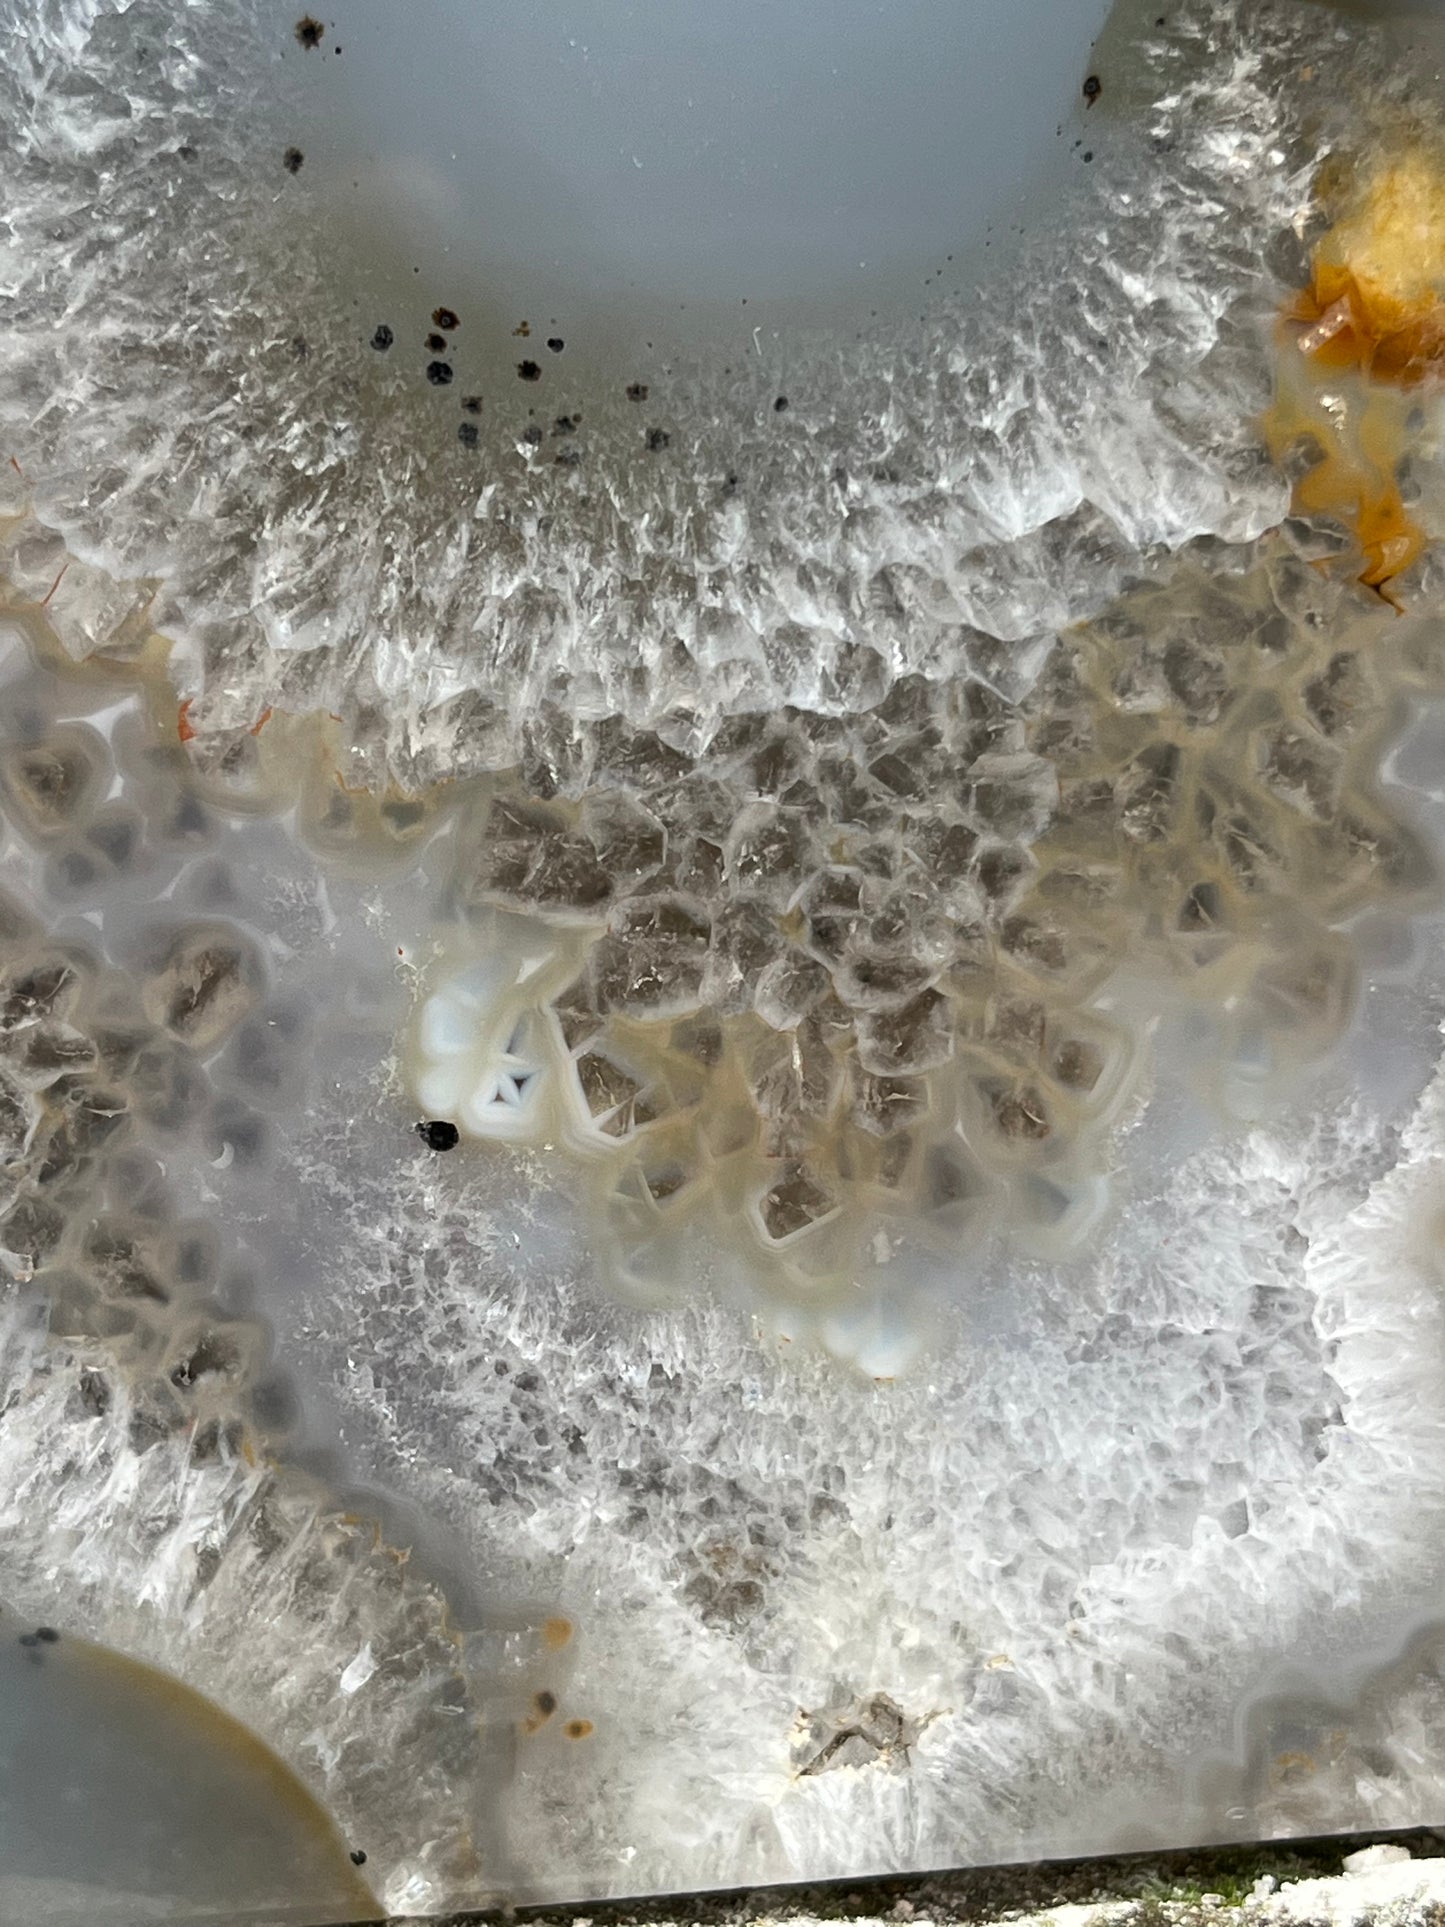

Norbert's Crystals & More
Enhydros Achát Geóda
Enhydros Achát Geóda
Nem sikerült betölteni az átvehetőségi adatokat
Enhydros Achát Geóda
Az Enhydros achát geóda egy különleges ásvány, amelyet az jellemez, hogy belsejében folyadék zárvány található. Ezek a geódák több millió évvel ezelőtt alakultak ki, amikor a folyadékot tartalmazó vulkáni kőzetekben üregek keletkeztek, majd ezek lassan kvarccal, acháttal vagy más ásványokkal töltődtek fel.
Szerkezet:
-
- A geóda külső része általában durva, vulkanikus kőzet.
- Belső rétegei gyönyörű achát mintázatokkal és kristályos struktúrával rendelkeznek.
- Az enhydros jelző a benne található folyadékra utal, amely lehet víz, olaj vagy más természetes anyag.
- A zárványok sokszor apró légbuborékokat is tartalmaznak, amelyeket mozgatáskor láthatunk.
-
Fizikai tulajdonságok:
- Keménység: 6,5–7 a Mohs-skálán.
- Szín: Színekben gazdag, gyakran fehér, szürke, barna vagy sávos mintázatokkal.
- Áttetszőség: Részben átlátszó az achát rétegek mentén.
Mikroszerkezet
-
Kvarc és kalcedon szerkezet:
- A geóda achát rétegei és kristályai szilícium-dioxidból állnak (SiO₂). Ez az anyag finoman kristályos vagy mikrokristályos formában van jelen.
- Az achát szerkezete szorosan összefüggő mikrokristályokból áll, amelyek nagy szilárdságot és ellenállást biztosítanak.
Származási Hely:
Uruguay: Különösen tiszta és jól rétegzett achát.
Spirituális Hatások:
Az enhydros achát geódákat régóta nagyra értékelik a spirituális és holisztikus gyógyászatban:
-
Tisztítás és érzelmi gyógyítás:
- Úgy tartják, hogy a bennük lévő ősi víz az érzelmi terhek tisztításának és a megújulásnak a szimbóluma.
- Segíthet a belső béke és harmónia megtalálásában.
-
Energiaáramlás:
- Az achát rétegei kiegyensúlyozzák a test és a lélek energiáit.
- A geóda belsejében rejlő folyadék egyfajta "életelixírként" működhet, amely az áramló energiát jelképezi.
-
Meditáció és intuíció:
- Támogatja a mélyebb meditációs állapotokat és az intuíció fejlesztését.
- Kapcsolatot teremthet a természet ősi erejével.
-
Kapcsolat az elemekkel:
- A víz elem révén kapcsolódik az érzelmekhez, az áramláshoz és a rugalmassághoz.
Ez a komplex szerkezet teszi az enhydros achát geódát nemcsak geológiailag, hanem esztétikailag és spirituálisan is különlegessé. A folyadék jelenléte, a koncentrikus achátréteg.








KRISTÁLYOK
✨ A kristályok a Föld szíve – ősi energiák, amelyek vezetnek, védenek és emelnek. ✨
Minden kristály egyedi, akárcsak te: segít felfedezni a belső erődet, megtalálni az egyensúlyt, és megteremteni azt az életet, amelyről álmodsz. Légy nyitott, és hagyd, hogy a természet csodái inspiráljanak a mindennapokban! 🌿💎
Termék beszámolók
-
Abigél
Nagyon örülök, hogy megkaptam az ásványt! Az energia, amit sugároz, azonnal érezhető volt. A kristály szépsége lenyűgözött, minden apró részlete tökéletes. Az ásvány valódi kincset jelent számomra, és az, hogy hozzá tartozik a részletes tudás, még inkább értékessé teszi. Biztosan visszatérek még a jövőben!
-
Péter
Nagyon elégedett vagyok a vásárlásommal. Az ásvány nagyon szép. A minőség teljesen rendben van, és a hozzá tartozó információk segítenek még inkább megérteni a kristály erejét. Kiváló termék!
-
Marcel
Az obszidián termék fantasztikus! Azonnal érezhető az energiája – védelmet és stabilitást ad. Nagyon elégedett vagyok vele, igazi erőt sugároz, és segít az érzelmi blokkok feloldásában.